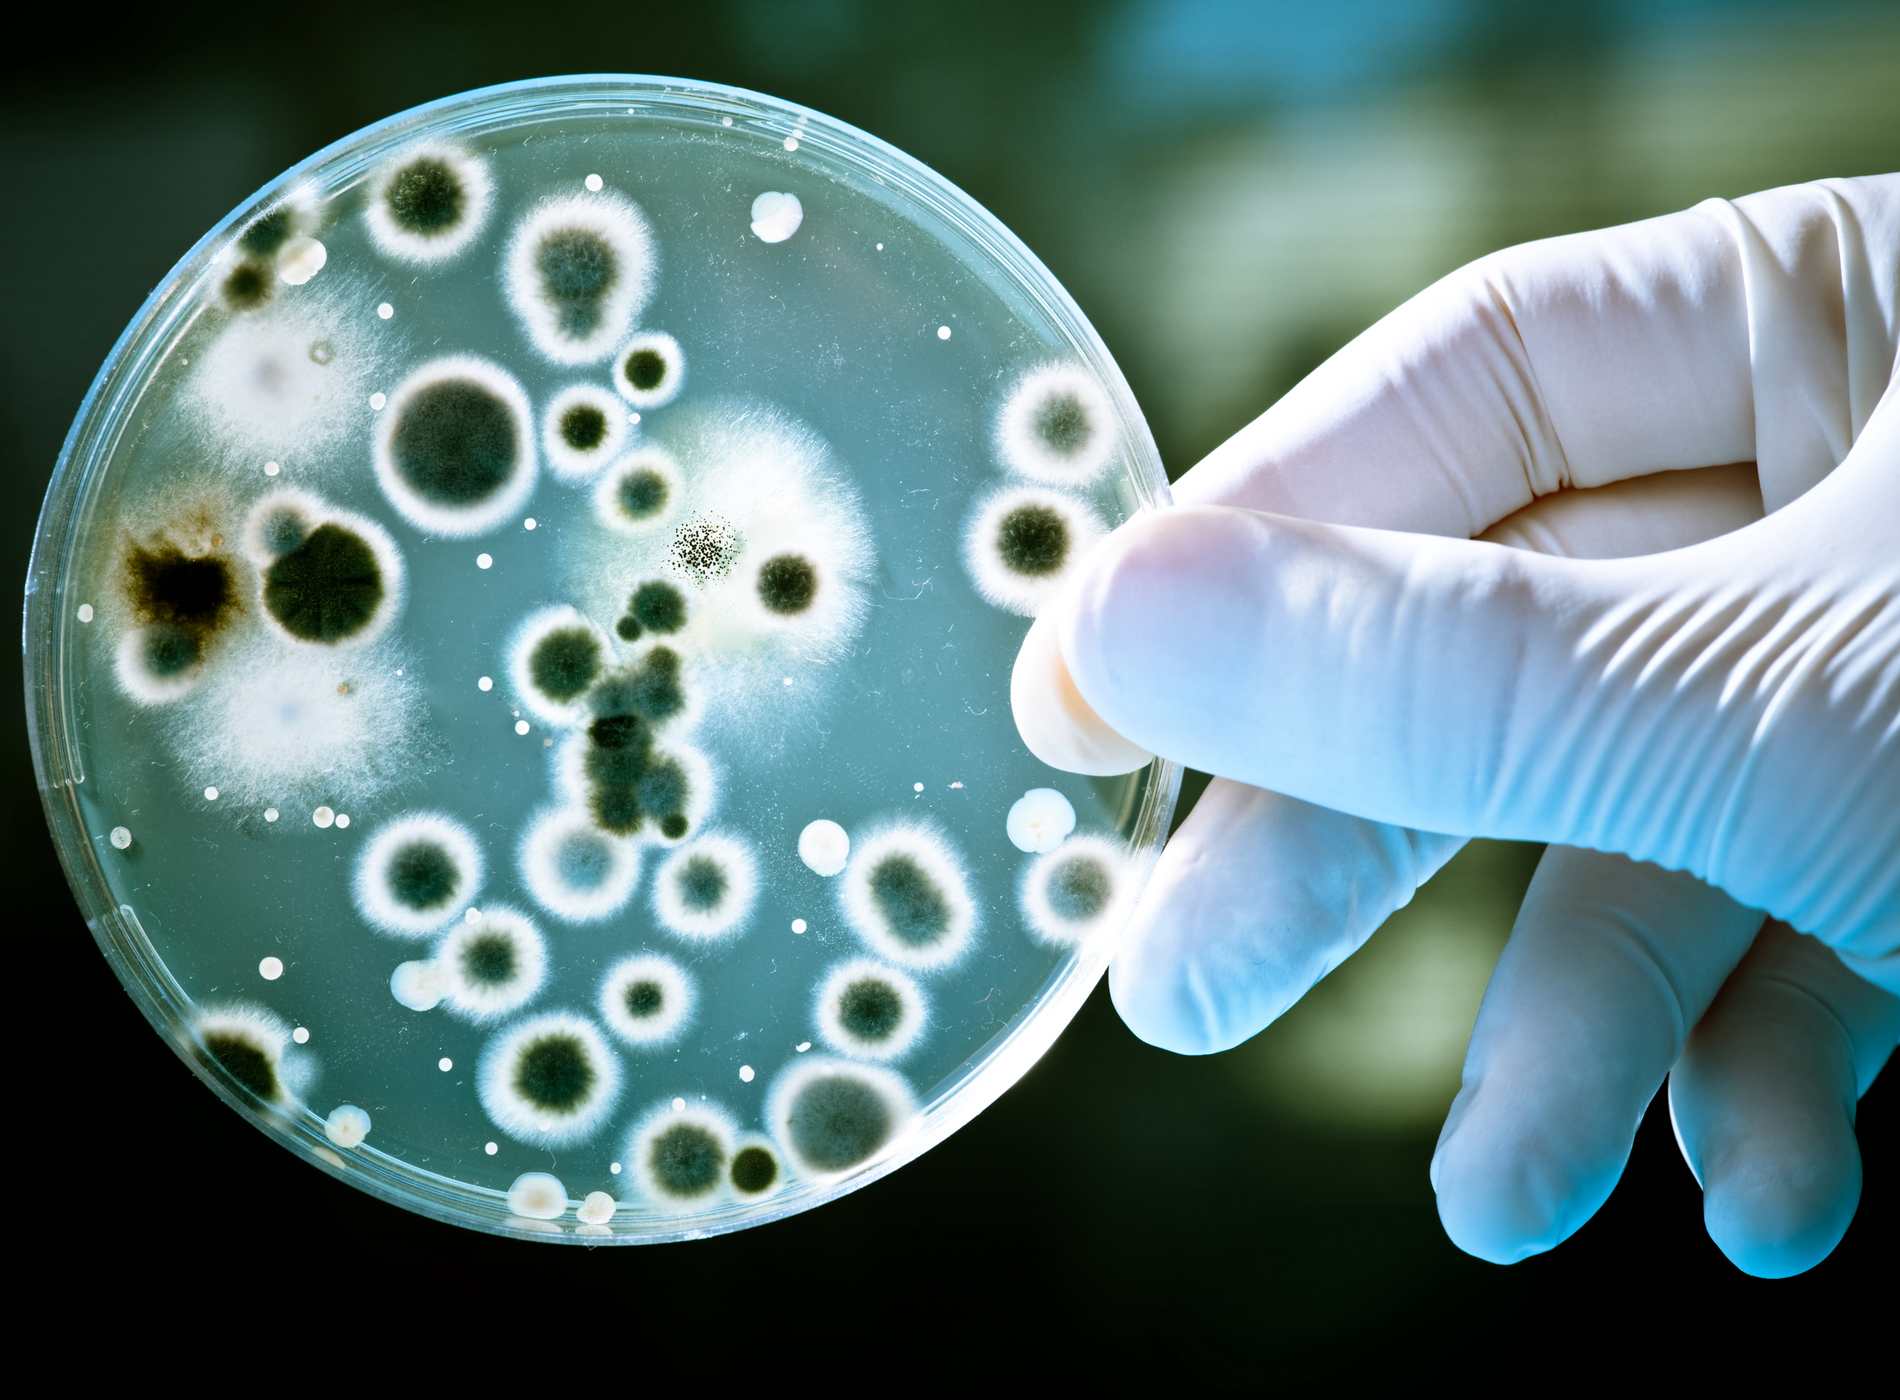

BUSINESS
38億年の微生物と醸造の歴史
目次
「醸(かも)す」
『もやしもん』は、微生物が見える主人公の農大での生活を描き、日本酒やビールなどの醸造過程とそこに登場する菌に焦点を当てた漫画だ。菌たちがキャラ化され生き生きと躍動し、それによって様々な恵みを享受したり振り回される人間登場人物たちの姿は一大ブームを起こした。
多様な作用をもたらす存在として広く知られた微生物は38億年前から存在しており、自然発酵は人類の歴史よりも古くから存在していた。紀元前6千年頃には醸造が行われていたという考古学的証拠もある。
かつて醸造物の製造過程で起こる発酵は、自然に起こる神秘的な現象であると考えられ、神が宿ることで起きると考えられていた。近代に入り顕微鏡の発明によって微生物の”発見”が起こり、その仕組みが解明され微生物学が発展するまで、そう信じられてきたというのは興味深い。
そもそも醸造とは、微生物や酵素の働きで物質を変換したり食品を製造することである。
微生物の種類や効果は多様で、様々な方法で様々なものが太古より作られ続けてきた。例えば麹を使って、穀類などを微生物で発酵させて酒、味噌、醤油、食酢などを造ったり、酒類(アルコール飲料)も製造できる。またイースト菌はパンを、サッカロミスという酵母はビールを作る。そして近代では抗生物質など医療品やアルコール燃料などに転用する場合もあり、醸造の営みは世界中の文明と、そして日本人とも密接に結びついてきた。
ここでは、醸造と人類史、そして発酵とその哲学、醸造とテクノロジーについて、多角的に掘り下げ、その奥深さの一端にふれてみたいと思う。
微生物38億年の醸造史

古代より、人間は発酵の仕組みを利用してきたが、その始まりは偶然だったと考えられている。
古代文明の時代からあるビールやワインは、麦芽やぶどうの糖をサッカロミセスという酵母が発酵して造り出した。食料を保存するために容器に入れて放置したところ酵母や細菌が繁殖し、結果として発酵食品が生まれたと考えられるだろう。
醸造は紀元前6千年頃から行われており、考古学的には中国、古代エジプトなどの新興文明でビールが醸造されていたことが示されている。メソポタミアでは最古の文字体系である楔形文字の文書の中に、さまざまなビールのレシピが記され、アリルのビール領収書という石板には、紀元前2050年醸造家から「最高級のビール」を購入した記録が残されている。当時から酒は、人々に特別な喜びを与えていたことが生き生きと伝わってくる。
メソポタミアにおいて、醸造の技は神聖な保護を受けた唯一の職業であり、酒の守護神も全て女性神であった。また産業化以前の社会では、女性が主に醸造を担ってきた。これは日本でも同じで、杜氏はもともと「刀自」と書いて女性を指していた。古代の日本で酒はまつりの度に神々に仕える乙女達によって造られ、それを束ねる女性を「刀自」(とじ)と呼んでいた。酒造りが産業化し大桶など力仕事の要素が加わり、男性中心の仕事に移り変わったが、発音はそのまま「杜氏」の字があてられたという。
刀自が造っていたのは映画「君の名は」などにも出てくる「口噛みの酒」で、穀物を口で唾液と一緒に噛んで供えておき、空気中から野生の酵母を取り込み発酵させる原始的な醸造法が主流だった。こう捉えると、無数の微生物の働きによって無かったものが姿を現すかのような神秘的な現象と、胎内で生命を作り出す女性がその媒質になっていたということは大変興味深い。

特定の糖分を含む穀物は、空気中の野生酵母によって自然発酵を起こすため、どの地域でもビールに似た飲み物が独自に発展していった。発酵自体の最も古い考古学的証拠はイスラエルの洞窟で発見された約13,000年前の「おかゆ状のビール」である。また、果物や蜂蜜から造られた初期のアルコール飲料は、中国で紀元前7000〜6600年頃のものが確認されている。ワイン造りはコーカサス地方のジョージアで紀元前6000年頃、また約3900年前に書かれたビールの女神を讃えるシュメールの詩には現存する最古のビールのレシピが含まれ、パンを通して大麦から造る過程が記されている。
ヨーロッパでも、新石器時代(約5000年前)にはすでにビールが家庭規模で醸造されていた。産業革命期に、その製造は手工業的なものから工業的生産へと移行し、その後温度計などの発明によって醸造管理が容易になり、ヨーロッパのビール醸造は大きく変化していった。

紀元前に醸造が始まっていた頃、日本は縄文中期で、ブドウなどの天然酵母が自然に発酵した果実酒の類が飲まれていたと想定されている。弥生時代 に入ると稲作とともに米麹を利用した酒造りが始まり、これが日本にとって最初の清酒醸造となった。
最初は蒸し米を放置したら酒になったという自然発生的なものだったはずだが、その後麹による糖化ともろみによるアルコール発酵という別々の現象に着目し、それを組み合わせる技術が生まれた。
『三国志』の中にある「魏志倭人伝」は、3世紀後半の倭国(邪馬台国)の様子が記録されているが、その中に既に酒にまつわる話が載せられている。大和朝廷の時代に酒造は神に捧げる神事として執り行われた。748年 には 古文書に「酒屋」の文字が初めて出現する。これは酒造が産業化したことの大きな一歩といえる。
江戸時代には酒造業や醤油醸造業は、幕府や藩を支える主要な産業として機能し、明治時代においては生活の欧風化が進むも日本酒や醤油などの調味料の需要は増大し、かつビールなどの多様な酒の生産も盛んになり始めた。そこに目をつけた明治政府は酒税・醤油税を徴収して財源不足を補おうとした。この目論見は当たり、大正中期まで酒税の税収は地租や法人税を上回るほどであったという。酒税は富国強兵のための殖産興業の資金や戦争の軍費として使われ、日本の近代化に大きく貢献した。
一方西洋から微生物の研究が伝わり、発酵のメカニズムが明らかにされて技術革新が進んだ。

オランダの科学者レーウェンフックの顕微鏡開発により、微生物が初めて”発見”された。その微生物が発酵を担っていることは、その200年後、フランスの科学者パスツールによって実証され、また今日に欠かせない殺菌法も生み出した。ドイツの科学者コッホは寒天培養地で一つの微生物のみを選別する方法を開発し、これも微生物学の発展に寄与し、産業革命後、病から人々の命を飛躍的に救った抗生物質のペニシリンは、1982年にペニシリウムという青カビを発酵させたものから開発された。
現在、醸造業は世界的な産業となっており、巨大多国籍企業が市場を支配する一方で、ブリューパブから地域のブルワリーまで、何千もの小規模生産者が存在する。ビールだけでも、 年間の販売量は1330億リットルを超え、2006年時点で世界全体の売上高は2945億ドルに達している。
菌塚に弔う無数のいのち

2022年12月14日付けで「Nature」に発表された研究によれば、運動好きのマウスの腸内には、運動への意欲を高める信号を脳に送る細菌がすんでいることがわかった。人間と同じように、マウスの中には、あまり動かないものも、回し車で走りたがるものもいる。これらが腸内細菌による影響だとすれば、人間にも同じことが言えるのでは、というのが1番新しい知見だ。
またマウスの臆病な個体や社交的な個体などの行動特性を腸内細菌で見分けることが可能で、腸内細菌とマウス社会的行動の関係も研究が進んでいる。こうした発見は人間の自閉症的行動の改善にも影響を与えることが示唆されている。「腸が第二の脳」と言われるようになったことで、醸造や発酵食品への世界的な注目の高まりは必然的なものだろう。微生物たちと人間との関わりは今新しいフェーズに入ろうとしているようだ。
また、西洋の衛生学による社会通念である「消毒による無菌化」が現代人を脆弱にしているという科学的意見も注目されつつある。
ボストンを拠点とするバイオテクノロジー企業AoBiomeはアンモニア酸化細菌(Ammonia Oxidizing Bacteria =AOB)を含む美容水などを販売している。エンジニアのデイヴィッド・ウィットロックは2001年「なぜ馬は地面に転がるのか」が気になり、馬小屋近くの土壌サンプルを調べ、「Nitrosomonas eutropha(ニトロソモナス・ユートロファ)」という細菌が馬や他の脊椎動物にとって重要な機能を持つと考えた。この理論を検証するため、ウィットロックは細菌を水に懸濁させ、自分の体に塗布してから入浴をやめ、AOBが自分の皮膚に定着するのを試み、彼はその後2015年のビジネスインサイダーの記事で15年以上シャワーを浴びていないと語っていた。
私たちの腸と同じように、皮膚にも多様な細菌や微生物が生息する豊かな生態系があり、そのほとんどは無害で、中には私たちの体にとって有益なものもある。たとえばAOBは多くの動物の皮膚に存在し、汗に含まれるアンモニアを分解しているものの、現代人の皮膚からはほとんど見つからない。しかし唯一、アマゾン熱帯雨林の先住民族ヤノマミ族の皮膚からはAOBが検出されている。これは私たちが日々石けんやシャンプーで体を洗うたびに、AOBのような細菌を洗い流してしまっていることに由来するだろう。これは「衛生仮説(hygiene hypothesis)」と呼ばれる考え方にも関係している。この仮説によれば、幼少期に微生物に触れる機会が少ない人ほど、免疫系が十分に発達せず、アレルギーやその他の疾患を発症しやすいとされている。
AOBはニキビなどにも効果を現すことは既に科学的にも証明されており、AoBiomeがリサーチパートナーを務めるMother Dirt社は、「AO+ミスト(AO+ mist)」という、AOBを含むスプレー製品を開発し、まさに馬が泥を浴びるように、細菌を日々の生活で浴びることができる。
私たちの極端で“清潔強迫的”な習慣を抜け出す日も近い?のかもしれない。
京都市の比叡山西麓にある曼殊院に、微生物を供養するための「菌塚」がある。
醸造や発酵工業では、発酵生産が終わると殺菌・滅菌するし、微生物を扱う大学の研究室では、実験後には微生物をオートクレーブで滅菌することが義務付けられている。そうした人類への貢献の後に殺められた菌たちに感謝と供養をするための「供養塚」である。また枯草菌の遺灰がそこに納められていることから、これは菌の「お墓」でもある。
情報学者ドミニク・チュンがWIREDに寄稿したコラムによれば、菌塚にある表記「人類への貢献のために犠牲となった無数億の菌の霊を祀る」というメッセージを英訳し海外で紹介すると、どっと笑いが起こり、様々な研究者が菌塚について質問をしに来る等大きな反響があったという。
こうした仏教の「不殺生戒」や神道の世界観に由来する、人間ではないものに霊性を認めるアニミズム思考は、和辻哲郎の『風土』で自然を飼いならす、と表現されたヨーロッパの一神教の精神性をそのままに生きとし生けるもの複雑さを制御しようとするアメリカ的価値観からすれば、驚きを持って受け止められたのも頷ける。それと同時に、この日本独特のアミニズムの視座には、微生物と共存し、またその無数の生命体が作り出したものを私たちが食することで生じる醸造や発酵の生命の循環が在り、そこに日本人そのもの核心が込められているともいえる。
醸造を知り考えることは、私たち日本人の精神性の豊かさに触れることでもあるだろう。
菌の声が聞こえる

もやしもんで主人公沢木が菌が見える設定になった理由として、作者の石川雅之氏が酵素メーカー天野エンザイムでのインタビューで興味深い回答を行っていた。
『お酒のタンクのところに連れて行ってもらったときに「ほら、プチプチ言う音が聞こえるでしょう。私たちは菌の声を聞くんです」という実体験のお話を聞いたとき、「酒蔵の人が聞こえるなら、実際に見えてもいいんじゃないかな、漫画だから」と発想が広がった感じです。』
杜氏などがもつ超能力のようなこの”菌の声を聴く”力だが、近年は科学技術の力を使い、実際に微生物たちが元気かどうかなど、菌の状態を簡単に知ることができるようになったという。
ただし未だに醸造は神の域のような非常な繊細な職人技によって生み出され、海外でも大変な人気を誇る『獺祭』の醸造では、純米大吟醸のみを機械による工程の自動化をほとんど行わずに造っていることも良く知られている。
それがある意味日本酒の付加価値の源泉でもあり、また人手不足の原因にもなっている。
現代の醸造業の課題は、国内需要の減少、後継者不足による技術継承の難しさなど多岐にわたっている。醸造家は中小企業が多いことから経営基盤が脆弱であるという構造的な問題があり、また、物流・税に関するバックオフィス業務の負担などが問題になるなど、その継続にはさまざまな障壁が立ちはだかっている。
こうした課題に対し、多くの醸造業は海外市場への展開を視野に入れて積極的に輸出や営業を行ったり、ITによる業務効率化を目指す動きがある。また杜氏の属人化の防止と業務の標準化という点も、なり手不足を考えると、今後検討が必要だろう。
IoTシステムによるセンシングデータの活用により、発酵温度の遠隔管理なども可能になるだろう。また麹菌や酵母菌などをAIが見分けて管理を行うようになるような未来はそう遠くないはずだ。
ただし、杜氏の職人技の結晶である暗黙知を表現するのは非常に困難でもある。
例えば、伝統的な製法である「生酛(きもと)」は、天然の乳酸菌を活用する手法であるため、マニュアル化することは不可能であり、味や品質は熟練の技にかかっている。この画一的な再現の困難さこそが、日本酒の魅力である部分は大きい。こうした醸造の過程でDXを推進する際には、杜氏や職人の想いと技を理解し、尊重することが大切だ。
最新技術でそれを補完し、製造現場から提供されたデータを学習したAIを、酒造りの微妙な調整に活用することで、熟練技能者の技能を模倣していくことは急務だが、そうした属人性がもたらす高付加価値についても改めて再考し、海外でのブランディングなどで訴求してゆくこともできるだろう。
巡る、いのち。

微生物は、わたしたちより太古の昔から存在し、偶然の働きから享受した甘美な飲み物や食べ物を食べて体内に取り込むことで私たち人類は元気になってきた。その膨大な数の命が巡る究極の循環のなかに、命そのものが活性化するような、ある種の精神性のようなものを内包している。だからこそ、日本人はここまで醸造にこだわってきたのかもしれない。
38億年間ずっと命を生み出し続けてきた醸造の機能は、多少の自然界や人類の変化を箸にもかけず、ただ連綿とその働きを続けてゆく。その意味では常に変化や勃興があるテックよりも、醸造のほうが人類のインフラストラクチャであるだろう。
古来人間は発酵の過程に神の介在を見出し、神秘を感じてきた。
今や顕微鏡でその姿が”見える”ようになり、その生命の群体の豊かさに科学をもって近づくことができるようになってきた。その恵みにふれ、操り、新しいものを生み出して、食す。その連環の美しさを、次世代の人々に伝えてゆくことが、私たちの使命だ。
参考文献
「食と農」の博物館 展示案内 No.58『醸造のふしぎ』-微生物が醸す世界-https://www.nodai.ac.jp/application/files/8914/8599/9979/58_01.pdf
【随縁随意】微生物に感謝(曼殊院菌塚)-中濱 一雄
生物工学会誌 第100巻 第3号
https://www.sbj.or.jp/news/news_sbj_10003_zuien_zuii_20220325.html?doing_wp_cron=1762798898.2763431072235107421875I ‘showered’ in bacteria for a week, and it totally changed my definition of clean
Business Insider
https://www.businessinsider.com/i-showered-myself-in-bacteria-for-a-week-2015-11AOBiome
https:// www.aobiome.com「微生物との共生」レポート(2/2)思想としての発酵に向けて
ドミニク・チェン WIRED
https://wired.jp/series/ferment-media-research/03_ncc-2/「微生物との共生」レポート(1/2)思想としての発酵に向けて
ドミニク・チェン WIRED
https://wired.jp/series/ferment-media-research/02_ncc-1/この世界の仕組みを、想像力で解き明かす。<前編>
見えないもので世界はできている
https:// mienaimono.jp/ja/kouso_talk/003-1.html
伊藤 甘露
ライター
人間、哲学、宗教、文化人類学、芸術、自然科学を探索する者
